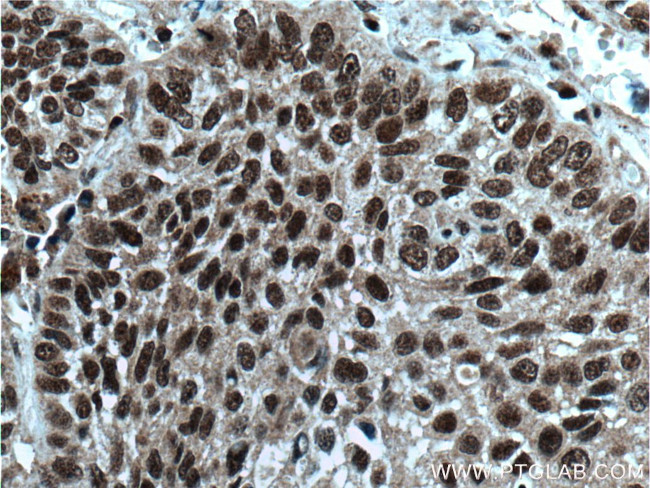
BANP Antibody in Immunohistochemistry (Paraffin) (IHC (P))

Search
Proteintech
BANP Polyclonal Antibody
{{$productOrderCtrl.translations['antibody.pdp.commerceCard.promotion.promotions']}}
{{$productOrderCtrl.translations['antibody.pdp.commerceCard.promotion.viewpromo']}}
{{$productOrderCtrl.translations['antibody.pdp.commerceCard.promotion.promocode']}}: {{promo.promoCode}} {{promo.promoTitle}} {{promo.promoDescription}}. {{$productOrderCtrl.translations['antibody.pdp.commerceCard.promotion.learnmore']}}
产品信息
16393-1-AP
种属反应
已发表种属
宿主/亚型
分类
类型
抗原
偶联物
形式
浓度
规格
纯化类型
保存液
内含物
保存条件
运输条件
产品详细信息
Immunogen sequence: VRCAVPGRR QNTIVVKVPG QEDSHHEDGE SGSEASDSVS SCGQAGSQSI GSNVTLITLN SEEDYPNGTW LGDENNPEMR VRCAIIPSDM LHISTNCRTA EKMALTLLDY LFHREVQAVS NLSGQGKHGK KQLDPLTIYG IRCHLFYKFG ITESDWYRIK QSIDSKCRTA WRRKQRGQSL AVKSFSRRTP NSSSYCPSEP MMSTPPPASE LPQPQPQPQA LHYALANAQQ VQIHQIGEDG QVQVIPQGHL HIAQVPQGEQ VQITQDSEGN LQIHHVGQDG QVLQGAQLIA VASSDPAAAG VDGSPLQGSD IQVQYVQLAP VSDHTAGAQT AEALQPTLQP EMQLEHGAIQ IQ (119-469 aa encoded by BC009424)
靶标信息
This gene encodes a protein that binds to matrix attachment regions. The protein forms a complex with p53 and negatively regulates p53 transcription, and functions as a tumor suppressor and cell cycle regulator. Multiple transcript variants encoding different isoforms have been found for this gene.
仅用于科研。不用于诊断过程。未经明确授权不得转售。
生物信息学
蛋白别名: BEN domain-containing protein 1; Btg3-associated nuclear protein; Protein BANP; Scaffold/matrix-associated region-1-binding protein; unnamed protein product
基因别名: BANP; BEND1; SMAR1; SMARBP1
UniProt ID: (Human) Q8N9N5
Entrez Gene ID: (Human) 54971